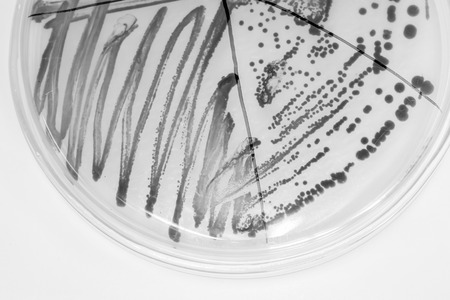
colony of becteria in petridish in microbiology laboratory with black and white conceptの写真素材

写真素材 - colony of becteria in petridish in microbiology laboratory with black and white concept
作品情報
colony of becteria in petridish in microbiology laboratory with black and white concept
- ID:83857936
- 作品種別:写真
- 作者名:thitiya mangprayool
キーワード
- agar
- antibiotic
- bacteria
- bacterial
- biology
- biotechnology
- blue
- chemical
- colony
- culture
- dish
- drug
- education
- experiment
- experimental
- fungi
- grow
- growth
- healthcare
- investigation
- lab
- laboratory
- macro
- medical
- medicine
- microbiology
- microorganisms
- molecular
- organism
- penicillin
- penicillum
- petri
- plate
- research
- science
- slant
- strain
- study
- test tube
- tube
類似作品
bacterial colon...
Different bacte...
petri dish with...
microbial cultu...
Close-up detail...
bacteria colony...
Microscopic vie...
close-up of pet...
microbial cultu...
Scientist using...
close-up of col...
Bacteria growin...
microbial cultu...
microbial cultu...
Mold
detail of bacte...
Bacteria in a p...
petri dish fill...
blood sample in...
virus cells in ...
Close up of bac...
Backgrounds of ...
petri dish with...
Detailed view o...
Bud
Bacterial colon...
Laboratory petr...
Laboratory for ...
microbial cultu...
microbial cultu...
Colonies of dif...
Petri dish grow...
Colonies of dif...
microbial cultu...
Magnifying glas...
development, re...
Close up chande...
transgenic plan...
Petri dish with...
Petri dish with...
microbial cultu...
Examining Bacte...
Close up of bac...
Bacterial colon...
microbiology la...
petri dish with...
AI-generated 3D...
leftover red ca...
Hand with a glo...